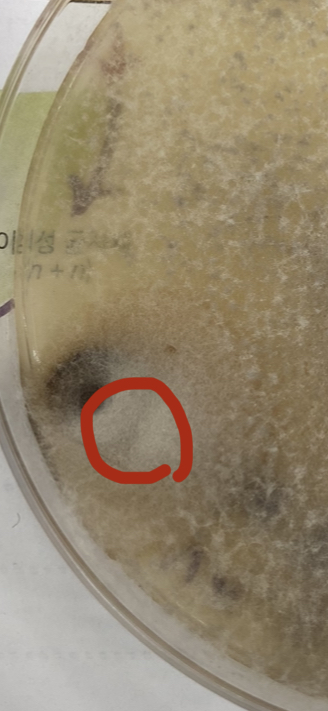

❍ 저희 제주농업기술센터 홈페이지를 방문해 주신데 대하여 감사드립니다.
❍ 귀하께서 질의(요청)해주신 부분에 대하여 다음과 같이 회신하여 드립니다.
❍ 현재 홈페이지에 게재된 현미경 사진에 대한 육안 관찰만으로는 곰팡이의 종류를 판단하기는 어렵습니다. 일부 곰팡이의 경우 현미경 관찰을 통해 판별 할 수 도 있으나, 동정이 힘든 경우 PCR검사를 통해 병원균을 분석해야합니다.
❍ 귀하께서 질의하신 흰줄무늬 달개비의 경우 농작물이 아니라 임산물(야생화, 자생란, 조경수, 분재, 잔디 등)로 분류가 되어 농작물을 대상으로 하는 저희 기관에서는 해당 식물에 대한 정보 취득이 어려워 산림청으로 문의를 하는 것이 바람직 할 것으로 보입니다.
❍ 이와 관련하여 추가적인 문의사항이 있으시면 제주농업기술센터 기술보급과 기술보급팀 농촌지도사 현도경(760- 7763)에게 전화주시면 성실하게 답변드리겠습니다.
❍ 저희 제주농업기술센터 홈페이지 방문에 감사드리며, 앞으로도 애로사항 및 궁금한 사항이 있으시면 언제든지 문의하여 주십시오. 감사합니다.